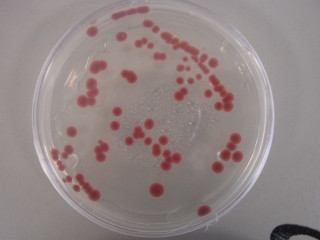
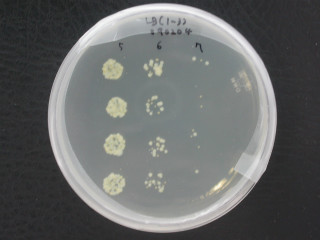

cfu(colony forming unit)은 하나의 cell에서 하나의 colony를 형성한다는 이론에서 출발합니다.
선택배지나 영양배지에 미생물을 도말하면 나중에 colony를 이루는데 이 수를 측정하면 배양액속의 cell수를 알 수 있습니다.
저는 도말법보다 조금 편리한 spotting법을 사용합니다. 도말봉으로 도말하는 방법보다 시간이 절감되고 하나의 평판배지에 다수의 시료를 만들 수 있어 비용과 시간이 절감됩니다. (단 도말법이 정석입니다.)
1. 준비물
크린벤취, 인큐베이터, 멸균기, 평판배지, 멸균증류수, 볼텍스, 시험관(마이크로튜브), 마이크로파이펫(1ml) 도말봉(마이크로파이펫 5ul) 팁 등
2. 도말법에 의한 cfu 방법
- 측정하고자하는 미생물의 종류에 따라 평판 agar배지를 만들어 놓는다.
- 측정하고자 하는 시료를 희석한다.
보통 배양액은 10^7~10^9정도의 cell이 포함되어 있기 때문에 희석은 10^5~10^7배 까지 희석한다.
(측정 배지에 colony가 너무 없어도 문제며 너무 많아도 겹쳐져서 오차가 생기기 때문에 적당하게 희석하여야 함.
보통 도말법은 50~100개 사이가 적당)
- 한개의 평판배지에 10^5희석액(0.1~1ml)을 선택배지에 떨어트린 후 도말봉을 이용하여 도말 한다.
- 위의 방법으로 10^6, 10^7 희석액을 각각 도말한다.
- 도말이 끝난 시료는 파라필름으로 잘 감싼 후 인큐베이터에서 1~2일 정도 배양한다.(균에 맞는 최적 온도 조건으로)
- 적당량의 colony가 나온 배지를 선택하여 colony를 계측한 후 승수를 계산한다.
계산법(도말법): 희석배율*colony 수/ml
<도말법에 의한 cfu측정, 광합성균>
문제 1 희석 배율 10^7인 시료 0.1ml을 넣고 도말한 후 위의 사진과 같이 나왔다.colony 수가 90개라면 cfu(cell/ml)는 얼마 일까요?>
2. spotting에 의한 cfu측정 방법
- 아래 그림의 원의 크기와 평판배지의 크기가 맞게 인쇄를 한다.
- 세로 3칸, 가로 4칸으로 세로는 희석승수 별로, 가로는 시료 수를 나타 낸다.
ex) 1, 2, 3, 4번은 10^5희석액, 5, 6, 7, 8번은 10^6희석액, 9, 10, 11, 12번은 10^7희석액
<그림 1. spotting 눈금표>
- 측정하고자하는 미생물의 종류에 따라 평판 agar배지를 만들어 놓는다.
- 측정하고자 하는 시료를 희석한다.
- 위 눈금표를 크린벤취위에 깔고 평판 배지를 그 위에 놓는다.
- 희석된 시료를 마이크로파이펫(5~20ul용량 사용)을 이용하여 5ul를 한방울씩 1, 2, 3, 4 칸안에 떨어트린다.
- 다른 희석 배율의 시료를 위의 방법으로 떨어트린다.
- 떨어트린 시료가 배지에 흡수가 되면 파라필름으로 감아서 인큐베이터에서 1~2일간 보관한다.
- 각 칸마다 colony 수를 계측하여 평균하여 승수를 계산 한다.
spotting법 계산법: 한칸의 미생물 수= 희석배율*colony 수 * 200(1000ul/5ul)
<미생물 배양액을 적당히 희석한다>
<희석한 미생물 시료(10^4, 10^5, 10^6희석액)을 만든 후 평판 배지를 눈금판 위에 놓는다.>
<희석 시료를 눈금판위에 5ul를 떨어트린다.>
<시료를 떨어트릴 때는 낙하균에 의한 오염을 방지하기 위하여 덮개를 살짝 연다음 떨어트린다.>
<인큐베이터에서 2일간 배양 후 사진(바실러스균주), 상부의 5, 6, 7은 희석수를 나타냄. (10^5, 10^6, 10^7) 10^6대의 colony수가
오차범위내에 들기 때문에 가운데 4개를 평균하여 계산한다.(10^5은 숫자가 너무 많아 계수가 불가능하며 10^7승은 숫자가 적어 오차가 심함.>